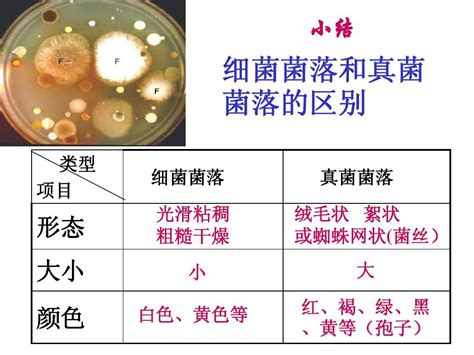

揭秘!生物界的微生物:细菌、真菌与病毒的异同全解析
作者:佚名 来源:未知 时间:2025-04-08
生物细菌真菌病毒的相同点和区别

在浩瀚的生物世界中,细菌、真菌和病毒作为微生物的重要组成部分,虽然个体微小,却对生态系统、人类健康乃至整个生物圈有着深远的影响。它们之间既存在诸多相似之处,又有着本质的区别。本文旨在全面解析这三类微生物的相同点和区别,帮助读者更深入地理解这一微观世界的奥秘。

一、生物细菌真菌病毒的相同点
1. 微生物范畴:
细菌、真菌和病毒都属于微生物,是肉眼难以直接观察到的微小生物体。它们广泛分布于土壤、水体、空气以及动植物体内,构成了地球上生命多样性的重要基础。

2. 非植物非动物类别:

这三者都不属于植物或动物界,而是独立于这两大生命类群之外的生物类别。它们在生物分类学上有着独特的地位。
3. 单细胞结构或缺乏细胞结构:
细菌是单细胞原核生物,真菌则包括单细胞(如酵母菌)和多细胞(如蘑菇)的真核生物,而病毒则没有细胞结构,仅由核酸和蛋白质外壳组成。尽管在细胞结构上存在差异,但它们都具备进行生命活动的基本要素。
4. 依赖宿主或环境生存:
无论是细菌、真菌还是病毒,它们都依赖宿主细胞或环境中的营养物质进行生存和繁殖。细菌和真菌在某些条件下可以独立生活,而病毒则必须寄生在活细胞中才能存活和复制。
5. 参与物质循环:
这三类微生物在自然界中扮演着分解者的角色,参与有机物的分解和无机物的转化过程,对维持生态平衡和物质循环具有重要意义。
6. 引发疾病:
部分细菌、真菌和病毒是人类的病原体,能够引起各种疾病。例如,结核杆菌可引起结核病,白色念珠菌可引起真菌感染,流感病毒则可引起流行性感冒等。
7. 生物技术应用:
细菌、真菌和病毒在生物技术领域有着广泛的应用。例如,细菌可用于生产抗生素、酶制剂等;真菌在发酵工业中扮演着重要角色;病毒则可用于制备疫苗、进行基因治疗等。
二、生物细菌真菌病毒的区别
1. 结构差异:
病毒:没有细胞结构,仅由核酸(DNA或RNA)和蛋白质外壳组成。这种简单的结构使得病毒能够轻松穿透细胞膜,进入宿主细胞进行复制。
细菌:单细胞原核生物,具有细胞壁、细胞膜、细胞质等结构,但无成形的细胞核。细菌细胞壁的主要成分是肽聚糖,这使得它们对许多抗生素敏感。
真菌:真核生物,细胞内有成形的细胞核和复杂的细胞器(如线粒体、内质网等)。真菌的细胞壁主要由几丁质或纤维素组成,与细菌和病毒的结构存在显著差异。
2. 大小对比:
病毒:是微生物中最小的生命体,直径通常在几十到几百纳米之间。
细菌:大小通常比病毒大,直径一般在0.5-5微米之间。
真菌:大小差异较大,单细胞真菌如酵母菌的直径与细菌相近,而多细胞真菌如蘑菇则可能达到几厘米甚至更大。
3. 繁殖方式:
病毒:依赖宿主细胞进行繁殖。病毒进入宿主细胞后,利用宿主细胞的生物合成机制复制自身的核酸和蛋白质外壳,然后组装成新的病毒颗粒并释放到细胞外。
细菌:通过二分裂方式进行繁殖。细菌细胞在分裂前会复制自身的遗传物质和细胞器,然后细胞壁从中间裂开形成两个子细胞。
真菌:主要通过孢子进行繁殖。真菌孢子是一种特殊的生殖细胞,能够在适宜条件下萌发成新的真菌个体。
4. 寄生性与独立性:
病毒:具有高度的寄生性,必须在活的细胞中才能存活和复制。病毒无法独立进行代谢和繁殖活动,必须依赖宿主细胞提供所需的物质和能量。
细菌:虽然某些细菌是寄生性的,但大多数细菌能够在多种环境中独立生活。它们能够利用环境中的营养物质进行代谢和繁殖活动。
真菌:与细菌类似,真菌也具有较强的独立性。它们能够在多种环境中生存和繁殖,包括土壤、水体、空气以及动植物体内等。
5. 感染症状与治疗:
病毒感染:症状通常表现为咽痛、流涕、肌肉酸痛等全身症状。由于病毒寄生在细胞内且复制速度快,因此抗生素治疗无效。治疗病毒感染通常需要使用抗病毒药物或依靠自身免疫系统清除病毒。
细菌感染:可能导致发热、寒战、局部淋巴结肿大等症状。细菌感染可使用抗生素进行治疗,抗生素能够破坏细菌细胞壁或抑制细菌蛋白质合成从而杀死或抑制细菌生长。
真菌感染:可能引起红斑、丘疹、水疱等皮肤损害以及呼吸道、消化道等系统的感染。治疗真菌感染需要使用抗真菌药物,这些药物能够破坏真菌细胞壁或抑制真菌生长代谢活动。
6. 生态学与医学意义:
病毒:在生态系统中主要作为寄生物存在,对宿主细胞具有潜在的破坏性。在医学上,病毒感染是导致许多传染病的主要原因之一。
细菌:在生态系统中扮演着分解者、生产者(如硝化细菌)和消费者等多种角色。在医学上,细菌感染是导致许多感染性疾病的主要原因之一,同时也是抗生素研发的重要目标。
真菌:在生态系统中主要作为分解者和共生者存在。在医学上,真菌感染虽然相对较少见但治疗难度较大且易复发。此外,真菌还是许多工业发酵和食品加工过程中的重要微生物资源。
综上所述,细菌、真菌和病毒作为微生物世界的三大类群,在结构、大小、繁殖方式、寄生性、感染症状与治疗以及生态学与医学意义等方面存在着显著的差异。了解这些差异有助于我们更深入地认识这些微小生物体的特性和作用机制,从而为预防和治疗相关疾病以及利用这些微生物资源提供科学依据。
- 上一篇: 轻松学会:如何注册电子信箱
- 下一篇: 轻松学会:winimg的使用方法
































